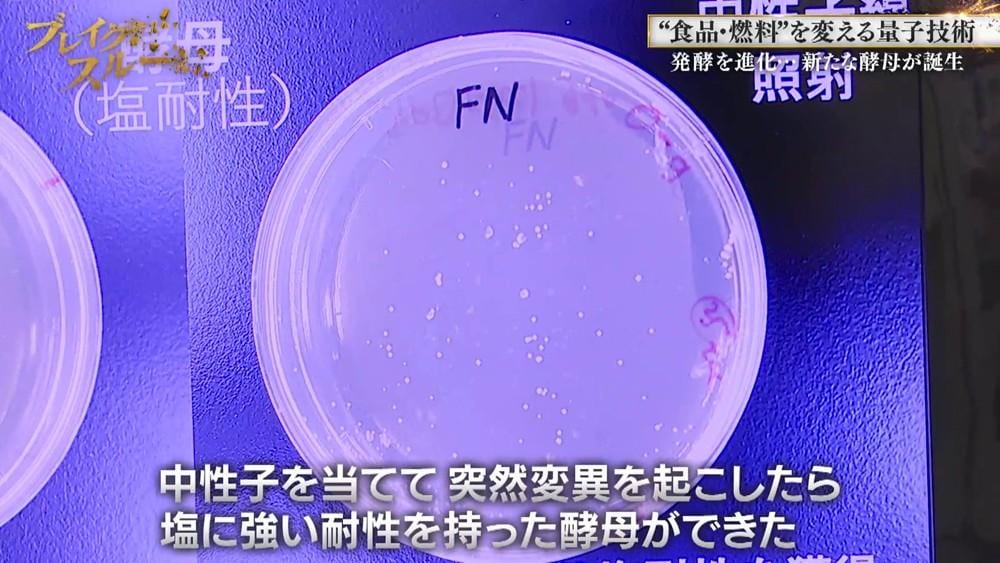
記事画像

“量子農業”で食料危機を救う!?常識を覆す“品種改良”の最新技術
更新日:
イチオシスト
ライター / 編集
イチオシ編集部 旬ニュース担当
注目の旬ニュースを編集部員が発信!「イチオシ」は株式会社オールアバウトが株式会社NTTドコモと共同で開設したレコメンドサイト。毎日トレンド情報をお届けしています。
11月8日(土)に放送した「ブレイクスルー」(毎週土曜 午前10時30分)を、「TVer」「ネットもテレ東」「テレ東BIZ」で無料配信中!
※「TVer」「ネットもテレ東」は期間限定無料配信、「テレ東BIZ」は無期限有料配信。
【動画】“量子農業”で食料危機を救う!?常識を覆す“品種改良”の最新技術

地球温暖化による異常気象で、世界の食料危機が深刻化。日本でも野菜価格の高騰にもつながっている。
そんななか、野菜や穀物などの品種改良にかかる時間を劇的に短縮する技術を開発したのが、クォンタムフラワーズ&フーズの菊池伯夫CEOだ。

世界で初めて、量子の1つである中性子のビームを種子などに放射することで、高確率で突然変異を引き起こすビジネスを開始。この技術を微生物の品種改良にも応用し、大手食品メーカーなどが発酵食品などへの活用を期待している。
さらに、世界的に利用の義務化が進むバイオエタノールなどの環境エネルギーの生産効率化も可能だという。
“量子農業”で世界の社会課題を解決しようと奮闘する開拓者に、ベストセラー作家・相場英雄が迫る!
出演:相場英雄(作家)、佐々木明子(テレビ東京アナウンサー)
開拓者:クォンタムフラワーズ&フーズ 菊池伯夫 CEO
ナレーター:谷田歩(俳優)
※「TVer」「ネットもテレ東」は期間限定無料配信、「テレ東BIZ」は無期限有料配信。
【動画】“量子農業”で食料危機を救う!?常識を覆す“品種改良”の最新技術

地球温暖化による異常気象で、世界の食料危機が深刻化。日本でも野菜価格の高騰にもつながっている。
そんななか、野菜や穀物などの品種改良にかかる時間を劇的に短縮する技術を開発したのが、クォンタムフラワーズ&フーズの菊池伯夫CEOだ。
世界で初めて、量子の1つである中性子のビームを種子などに放射することで、高確率で突然変異を引き起こすビジネスを開始。この技術を微生物の品種改良にも応用し、大手食品メーカーなどが発酵食品などへの活用を期待している。
さらに、世界的に利用の義務化が進むバイオエタノールなどの環境エネルギーの生産効率化も可能だという。
“量子農業”で世界の社会課題を解決しようと奮闘する開拓者に、ベストセラー作家・相場英雄が迫る!
出演:相場英雄(作家)、佐々木明子(テレビ東京アナウンサー)
開拓者:クォンタムフラワーズ&フーズ 菊池伯夫 CEO
ナレーター:谷田歩(俳優)
記事提供元:テレ東プラス
※記事内容は執筆時点のものです。最新の内容をご確認ください。
